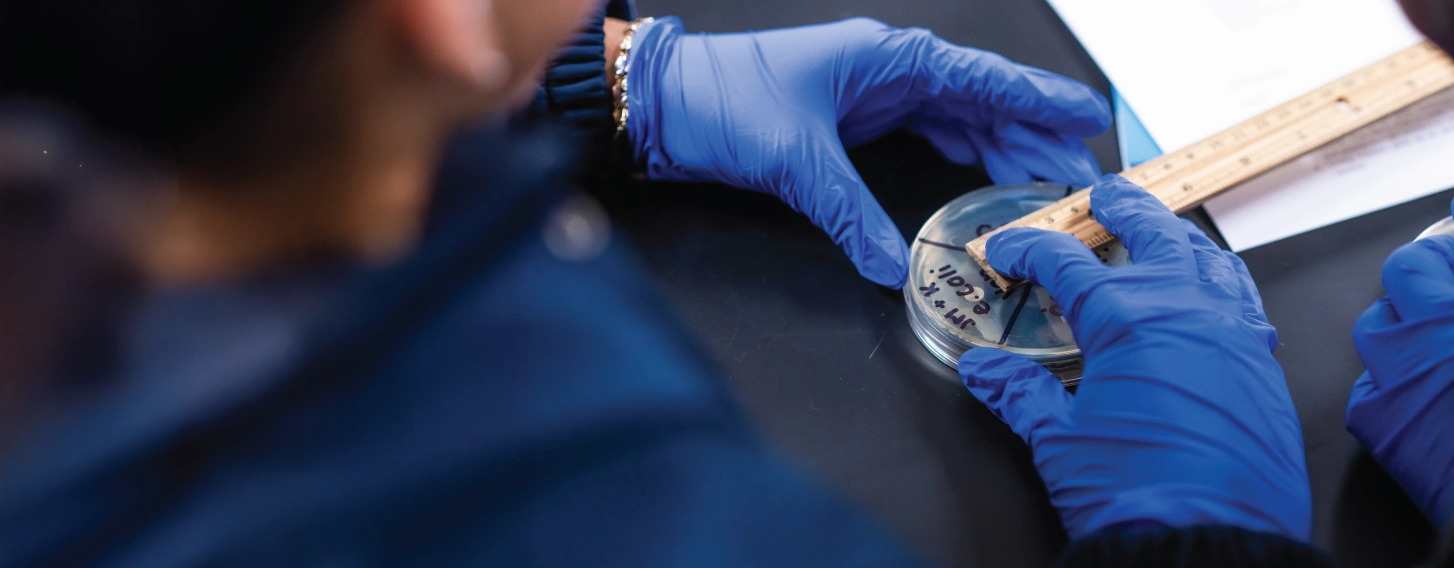
Hands holding an E. coli sample in a biomedical laboratory science lab.

Our BS in Biomedical Laboratory Science degree trains students through hands-on experience in data analysis and clinical practice. Career options in clinical labs, research and public health allow you to advance medical knowledge and improve patient care.
What is a BS in Biomedical Laboratory Science?
Reduce tuition by up to $24k
Why earn a BS in Biomedical Laboratory Science?
Learn to analyze medical tests and communicate data to medical providers. Gain in-clinic training at a healthcare provider as part of the curriculum, so students can seamlessly transition into the workforce directly after earning their degrees.
Hands-on learning
Our hands-on learning sharpens your skills, preparing you for a career in microbiology, virology, immunology or hematology.
Advanced opportunities
Develop anatomy and physiology skills in our cadaver dissection-based lab. It is a rare opportunity in your undergrad career.
Real-world research
Prepare for work in hospital lab work and cutting-edge research. From your second year, analyze data to diagnose conditions.
Industry-aligned curriculum
Our curriculum is designed to align with the expectations of employers in each respective field.
What you’ll learn in your BS in Biomedical Laboratory Science
Biomedical Laboratory Science teaches you to analyze and interpret medical tests. A one-year, site-intensive clinical laboratory practicum grows your skillset and prepares you for a career in microbiology, virology, immunology and hematology.
- Acquire in-depth knowledge of biomedical laboratory techniques, including specimen handling, microscopy and molecular diagnostics.
- Develop proficiency in laboratory safety protocols and quality assurance procedures to ensure accurate and reliable test results.
- Master the principles of medical microbiology, immunology and clinical chemistry to diagnose and monitor diseases.
- Enhance critical thinking and problem-solving skills through analysis of laboratory data and interpretation of results.
- Gain hands-on experience with state-of-the-art laboratory equipment and technologies used in biomedical research and clinical diagnostics.
- Collaborate effectively with healthcare professionals in interdisciplinary settings to provide accurate and timely laboratory support.
- Understand the ethical considerations and regulatory requirements governing biomedical research and clinical laboratory practice.
Explore biomedical laboratory science courses
- This degree requires you to complete a total of 120 credits
- Courses include 36 gen ed credits, 55 core credits, 29 elective credits, and 1 clinical internship
Sample courses
| Class Code | Class Title | Credits |
|---|---|---|
| BIOL 201 | Diversity of Living Systems + Lab | 4 credits |
| BIOL 211 | Intro to Microbiology + Lab | 4 credits |
| BIOL 300 | Biological Literature and Communication | 3 credits |
| BIOL 303 | Genetics + Lab | 4 credits |
| BIOL 305 | Immunology | 3 credits |
How much does a BS in Biomedical Laboratory Science cost?
The cost of your degree will depend on several factors, like scholarships, housing, meal plans, and transfer credits. New students also pay a $100 matriculation fee. You will also need to budget for books, supplies, materials, transportation, personal costs, loan fees, and other expenses. Explore the cost of attendance.
Full-time student living on campus
| Expense | By semester | By year |
|---|---|---|
| Full-time tuition (12-18 credits)* | $19,674 | $39,348 |
| Housing** | $4,313 | $8,625 |
| Food*** | $3,135 | $6,270 |
| Technology fee | $150 | $300 |
| Total direct charges (billable) | $27,272 | $54,543 |
*Based on 2026-2027 tuition and fees. Tuition and fees are subject to change each summer.
**This cost is estimated, actual housing cost will vary by student selections.
***Cost estimate based on 3 meals per day.
How much does campus housing cost?
When it comes to housing, St. Ambrose University offers diverse options to meet the needs of our students. From traditional dormitories to apartment-style living, there’s something for everyone. The cost of our housing will vary based on where you decide to live and the meal plan you choose.
St. Ambrose University is accredited by the Higher Learning Commission
Accreditation and recognition provide the assurance that we meet standards for quality of faculty, curriculum, learner services, and fiscal stability.
How does SAU support their biology students?
Our Biomedical Laboratory Science program is staffed by professionals who bring knowledge and diverse perspectives. They care about your academic success and personal goals and designed a strong curriculum to give you opportunities that support your goals.
Biomedical laboratory science faculty
Other support resources

Student Success Center
Access free tutoring, study groups, and supplemental instruction through our Student Success Center. Explore academic support services

Career services
Our Academic and Career Planning Center is ready to help you polish your resume and land a job or internship to launch your career.

Accessibility Resource Center
Whether you need classroom accommodations, alternative exam arrangements, or disability support strategies, our Accessibility Resource Center is here to help.
Are there scholarships available for a BS in Biomedical Laboratory Science?
SAU believes education should be accessible to all. We offer a variety of scholarships and financial aid options to make college more affordable for our students so they can succeed academically and financially.
Ambrose Advantage Scholarship
Through the Ambrose Advantage Scholarship program, a tuition-free education at St. Ambrose University is available to any Pell Grant-eligible Loans. Learn more about the Ambrose Advantage.
Merit-based and institutional scholarships
St. Ambrose offers excellent scholarships and grants based on your strong academic performance, your talent in fine arts or athletics, or your community involvement. Explore SAU scholarships.
Transfer credits
You may be able to transfer previous college credit to cover up to 25% of your degree, saving you significant time and money. Learn how to transfer credits.
Outside scholarships
We accept scholarships from outside sources, and there are tons of options out there. Start by searching for scholarships with criteria that match your specific talents or background. Need help? Here are a few websites to begin researching your options: Fastweb, College Board Scholarship Search, Scholarships.com, Peterson's Award Database, Scholly (app download)
What’s on campus for Biomedical Laboratory Science students?
Enroll in our Field Biology Research Learning Community/Inquiry in Action and take the lab to Nahant Marsh, one of the few remaining urban wetlands near the Mississippi. Join the Biology Club or Doctors to Bee (support for graduate school students).
Dedicated faculty
"The biology professors are all phenomenal. You're not just another student to them. I'm very happy to have worked with them for four years compared to what I could've had at a large university."
William Nemechek '25, BS in Biology
What are the BS in Biomedical Laboratory Science admission requirements?
Here are the admissions requirements for our BA in Biology.
- You must have graduated from an accredited high school or earned a GED.
- You must have a minimum cumulative, unweighted GPA of 2.5.
- You must provide an official high school transcript.
International student requirements
If you live outside of the U.S. there are different admissions requirements. Here’s what you’ll need:
- Official transcripts from secondary education
- A minimum 2.5 CGPA out of a 4.0 scale, or equivalent
- Proof of English language proficiency (minimum scores: TOEFL - 79, IELTS - 6.0)
- Copy of your passport and other documentation
What can I do with a BS in Biomedical Laboratory Science?
Your degree can help you reach your professional goals. SAU can never promise a career or particular outcome upon graduating. Here is a list of potential job titles, traits and settings graduates of our Biomedical Laboratory Science program could achieve.
Potential job titles
- Clinical Laboratory Scientist
- Medical Laboratory Technologist
- Research Laboratory Technician
- Biomedical Analyst
- Quality Control Specialist
- Public Health Laboratory Scientist
- Pathology Laboratory Technician
- Forensic Laboratory Technician
Potential employment settings
- Hospitals and medical centers
- Diagnostic laboratories
- Research institutions
- Biotechnology and pharmaceutical companies
- Public health agencies
- Government health departments
- Forensic laboratories
- Pharmaceutical quality control labs
Traits of Biomedical Laboratory Science majors
- Analytical
- Attention to detail
- Scientific knowledge
- Laboratory techniques
- Critical thinking
- Communication
- Ethical integrity
- Adaptability
Industry facts
- Around 1.8 million openings are projected each year, on average.
- Approximately 34% of Biology majors become healthcare practitioners and/or enter technical occupations.
For more information on biology employment and wages, visit the U.S. Bureau of Labor Statistics.
News and events at SAU
 >
>
April Discovery Day
Get a glimpse into life as a Fighting Bee during Spring Discovery Day
Read more

From Iowa to the Ruby Mountains: How St. Ambrose helped Hannah Reynolds ’23 find her calling
An SAU education helped biology major Hannah Reynolds '23 find and pursue her calling.
Read more

Celebrating faith and reason: St. Ambrose blesses anatomy lab
St. Ambrose University students, faculty and staff gathered in the lower-level hallway of Lewis Hall for a first blessing of the campus anatomy lab.
Read more


Become who you are meant to be
With more than 50 undergraduate and graduate programs, there’s something for everyone at St. Ambrose University! Explore our programs to find your place at SAU.